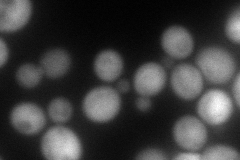
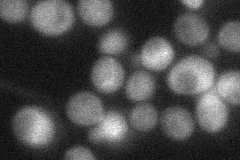

View description
Putative protein of unknown function with similarity to Tfc7p and prokaryotic phosphotransfer enzymes; null mutant shows alterations in glucose metabolism; GFP-fusion protein localizes to the cytoplasm and nucleus
Localization:
Intensity:
Fold change:
Significance:
-
C’ GFP library in SD

cytosol32.53 -
N' NOP1pr-GFP in SD

cytosol121.783 -
N' TEF2pr-mCherry in SD
cytosol110.715 -
N' NATIVEpr-GFP in SD
cytosol38.4764 -
N' TEF2pr-VC and Cyto-VN in SD

cytosol42.0564 -
C’ GFP library in SD+DTT

cytosol40.751.25No -
C’ GFP library in SD+H2O2

cytosol33.641.03No -
C’ GFP library in Starvation Media

cytosol34.971.07No -
C’ GFP library on the background of Pup2-DaMP

cytosol -
C’ GFP library on the background of CCT mutant

cytosol28.76710.884001No
